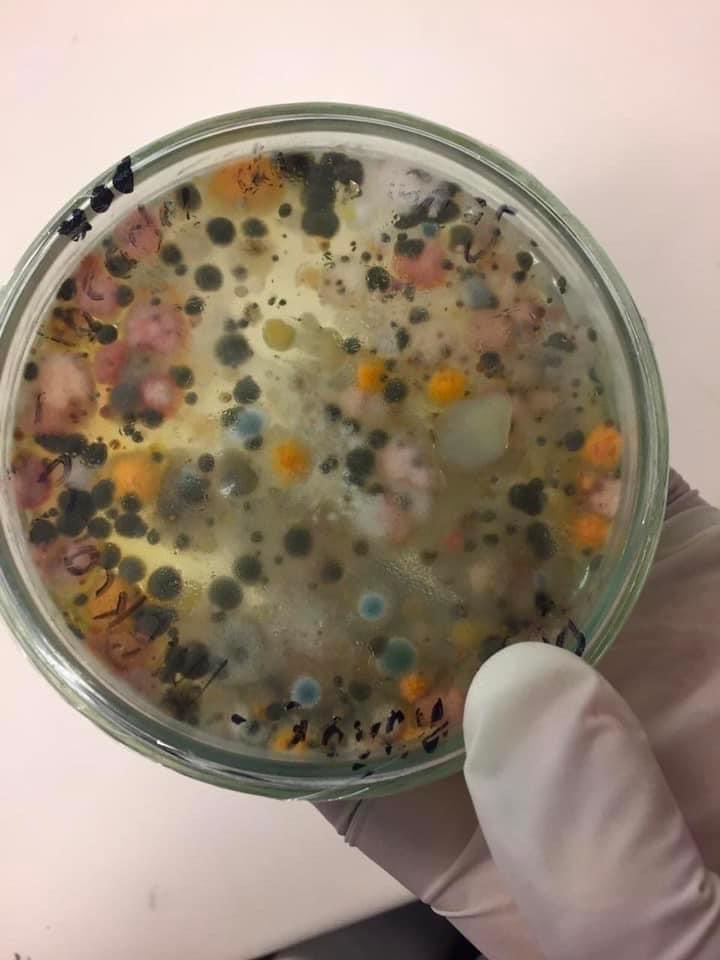
Esta imagen nos muestra un cultivo microbiano del aire procedente de secamanos de un baño público.

Se pueden lavar las manos las veces que quieran, pero si se secan en estos aparatos se ensuciaran nuevamente.

Solanyely S. Escobar
@solanyely_21
Socióloga, actriz de teatro social, escritora de poesía.
ID: 859599552
03-10-2012 12:23:25
287 Tweet
75 Takipçi
206 Takip Edilen


Gracias por las aclaraciones desde la organización del congreso. Aun así, las colectivas y activistas afrofeministas en el estado no podemos sinó seguir condenando q se convoque a mujeres no afro ni africanas a hablar de nosotras. Mónica Silvana González /❤️ no nos representa.


La directora general, Rita Bosaho, envía un mensaje en el día internacional de las mujeres afrodescendientes. 🤔📽 ¿Te has preguntado por qué las mujeres afrodescendientes están infrarrepresentadas en las instituciones o en los medios de comunicación?



📅 𝐉𝐔𝐄𝐕𝐄𝐒 20h - JAM DE POESÍA 🎙 Celebra el día de la mujer africana y afrodescendiente con nosotras en esta jam que organizamos con #REDAFROFEM. 🙌🏿 📩 Si quieres actuar, envía un email a [email protected]


¿Qué tipo de relaciones se establecen en un marco de racismo sistémico? ¿Nos oprimimos entre novies y amigues cuando está de por medio el factor étnico-racial? Reflexiono sobre ello en la última edición en papel de Pikara Magazine ¡Maravilla de número! Cómprenla y suscríbanse 😍

✅ #Feminismo #decolonial: una mirada desde los márgenes ☑️ Con Miriam Hatibi y Sara Cuentas y la moderación de Lucía Mbomío. 🗓 18 de octubre (19:00 CEST) 📍 Madrid ☑️ Organiza: La Coordinadora✳️ y La Casa Encendida ☑️ Inscripción previa, aforo limitado ➡️ bit.ly/3qVP5Kw


Di algunas claves del tema Vinícius en Aquí y ahora: - El deporte de élite es la punta del iceberg de algo cotidiano - Apenas ha habido consecuencias por el racismo en el fútbol - El papel de los medios, que pueden sumar o restar con esto. 'El Chiringuito' eligió lo segundo.




Listas para la mesa de debate de Warmi Rumi artistas contra el racismo en España, este miércoles 5 de octubre a las 12 hs Facultad de Bellas Artes de la UCM. Complutense Cultura Complutense bellasartesUCM


Hey!!! 🤎🤎🤎 Este sábado es el primer evento de ✨CONTRACULTURAL✨ el festival de cultura antirracista de SOS Racismo Madrid. Recordar que estáis aún estáis a tiempo de pillar vuestras entradas y ayudar en la difusión 🗣️🗣️🗣️ bit.ly/Contracultural… SOS Racismo Madrid Sala Clamores



Este miércoles 9 en La Parceria estará @gadyola presentando su nuevo single. La apertura de puertas es alas 20h. 🎟️Pueden comprar las entradas en entradium.com/es/events/agua… 💜Disfruta de los eventos del festival de la cultura antirracista: Contracultural, de SOS Racismo Madrid